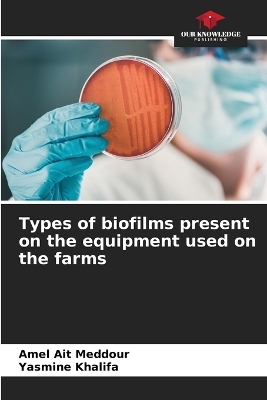
Types of biofilms present on the equipment used on the farms - Amel Ait Meddour, Yasmine Khalifa

Types of biofilms present on the equipment used on the farms
Seiten
2023
Our Knowledge Publishing (Verlag)
978-620-6-02556-6 (ISBN)
Our Knowledge Publishing (Verlag)
978-620-6-02556-6 (ISBN)
- Keine Verlagsinformationen verfügbar
- Artikel merken
Biofilm is a sessile microbial community on a living or inert surface. On dairy farms, biofilms inevitably form on wet equipment surfaces. There are two types, the positive biofilm consisting of flora of technological interest such as lactic acid bacteria that play an important role in preventing the adhesion of pathogenic microorganisms and the negative biofilm which consists of floraflora and pathogenic flora. The negative biofilm can detach from the equipment and contaminate the raw milk, causing alteration of its organoleptic quality and can be the cause of serious diseases
Full Name: AIT MEDDOUR AmelGrade: Master of Conferences-Class A
| Erscheinungsdatum | 22.06.2023 |
|---|---|
| Sprache | englisch |
| Maße | 152 x 229 mm |
| Gewicht | 97 g |
| Themenwelt | Naturwissenschaften ► Biologie ► Allgemeines / Lexika |
| Naturwissenschaften ► Biologie ► Mikrobiologie / Immunologie | |
| Schlagworte | farm workshops. • lactic acid bacteria • negative biofilm • positive biofilm |
| ISBN-10 | 620-6-02556-X / 620602556X |
| ISBN-13 | 978-620-6-02556-6 / 9786206025566 |
| Zustand | Neuware |
| Informationen gemäß Produktsicherheitsverordnung (GPSR) | |
| Haben Sie eine Frage zum Produkt? |
Mehr entdecken
aus dem Bereich
aus dem Bereich
Buch | Softcover (2024)
Wiley-VCH (Verlag)
CHF 55,85
Band 2: Elektrizität, Optik und Wellen
Buch | Softcover (2022)
Wiley-VCH (Verlag)
CHF 55,85
Vom Ursprung der Sexualitat zum modernen Menschen
Buch | Softcover (2025)
UTB (Verlag)
CHF 54,60


